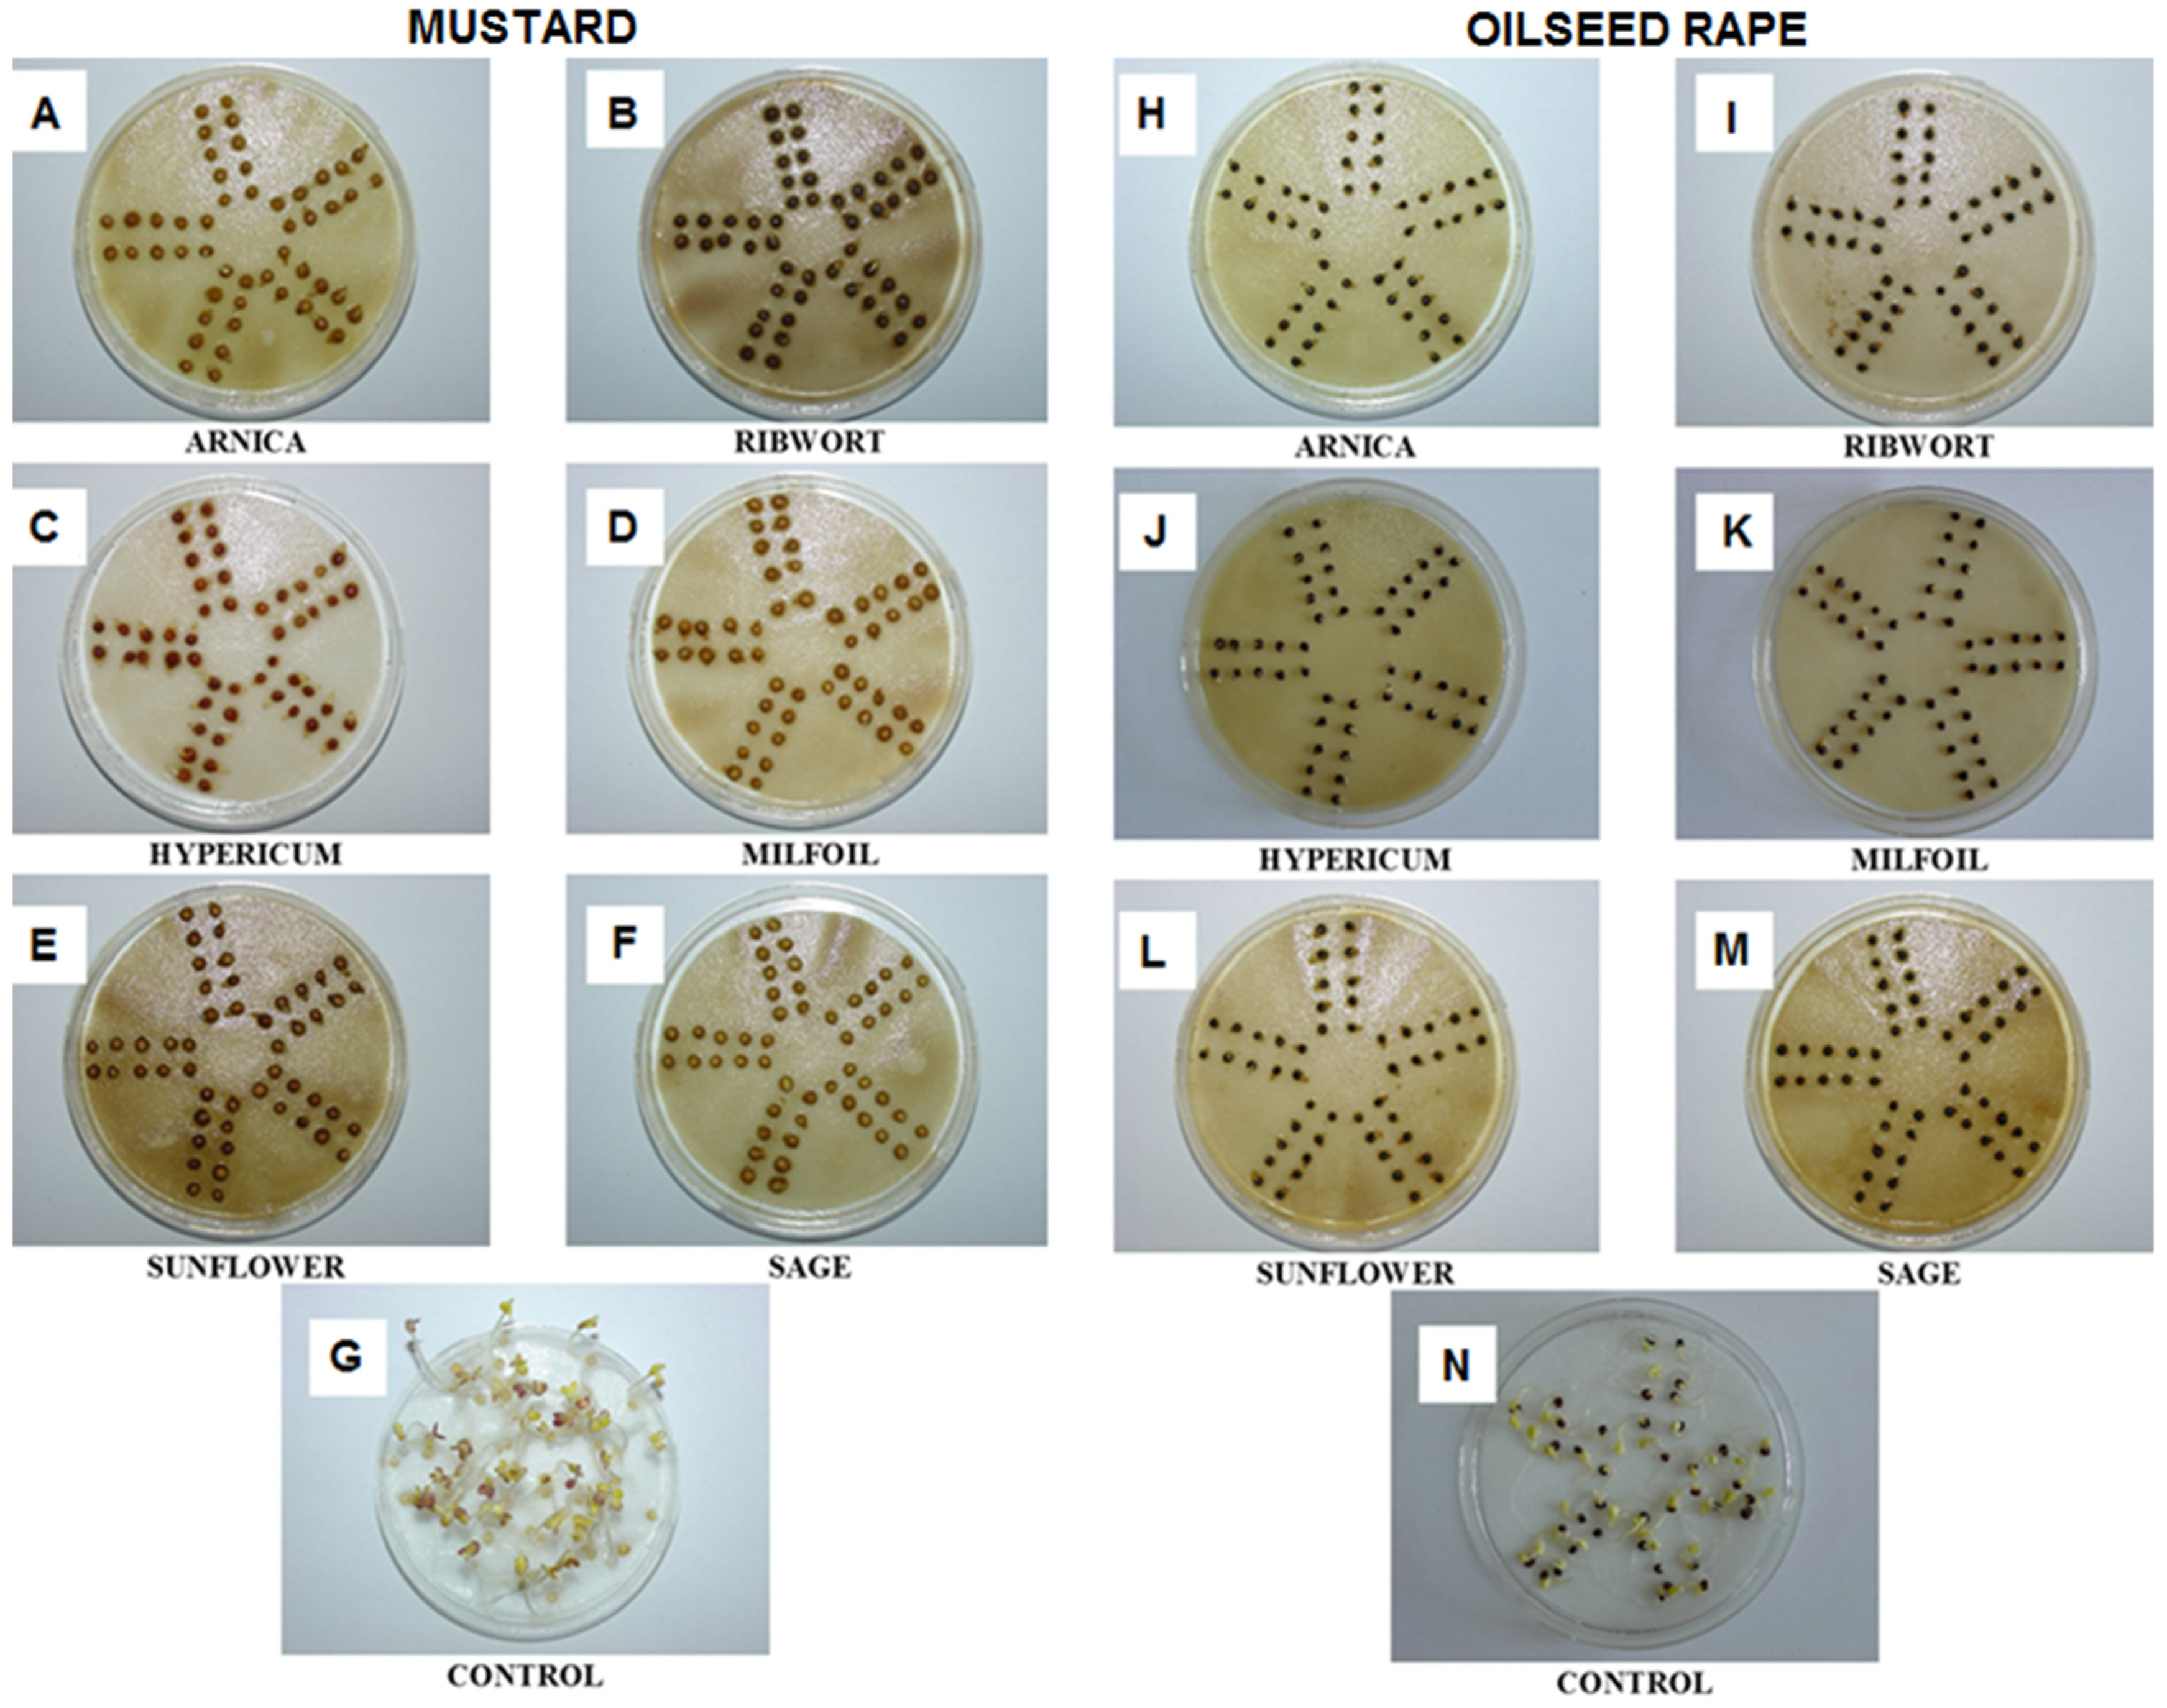
Agronomy 12 00110 g002 550

Phytotoxic Effects of Selected Herbal Extracts on the Germination, Growth and Metabolism of Mustard and Oilseed Rape
Abstract
:1. Introduction
2. Materials and Methods
2.1. Plant Material and Preparation of Plant Water Extracts
2.2. Experimental Design
2.2.1. First Experiment
2.2.2. Second Experiment
2.3. Measurements and Observations
2.3.1. Seed Germination
2.3.2. Estimating the Growth of the Young Seedlings
2.3.3. Plasmatic Membrane Permeability of the Seedlings
2.3.4. Calorimetric Measurements of the Metabolic Activity of Seedlings
2.3.5. FT-Raman Measurements of the Chemical Composition of the Cotyledons
2.4. Statistical Analysis
3. Results and Discussion
3.1. The Impact of the Herbal Extracts on the Germination of White Mustard and Oilseed Rape
3.2. The Impact of the Herbal Extracts on the Growth of White Mustard and Oilseed Rape
3.3. The Impact of Herbal Extracts on Cell Membrane Permeability in White Mustard and Oilseed Rape
3.4. Specific Thermal Power Curves and Amount of Total Heat in the White Mustard and Oilseed Rape Seedlings That Had Been Exposed to the Herbal Extracts (Metabolic Activity of the Seedlings)
3.5. Analysis of the Changes and Similarities of the Chemical Composition of the White Mustard and Oilseed Rape Seedlings That Had Been Exposed to Herbal Extracts
4. Conclusions
Author Contributions
Funding
Institutional Review Board Statement
Informed Consent Statement
Data Availability Statement
Acknowledgments
Conflicts of Interest
References
- Hance, A.J.; Holly, K. Weed Control Handbook: Principles, 8th ed.; Blackwell Scientific Publications: Oxford, UK, 1990; p. 582. [Google Scholar]
- Batish, D.R.; Arora, K.; Singh, H.P.; Kohli, R.K. Potential utilization of dried powder of Tagetes minuta as a natural herbicide for managing rice weeds. Crop Prot. 2007, 26, 566–571. [Google Scholar] [CrossRef]
- Sodaeizadeh, H.; Hosseini, Z. Allelopathy an environmentally friendly method for weed control. In Proceedings of the International Conference on Applied Life Sciences, Konya, Turkey, 10–12 September 2012; Nejadkoorki, F., Ed.; IntechOpen: London, UK; p. 387. [Google Scholar]
- Bajwa, A.A.; Ehsaullah Anjum, S.A.; Nafees, W.; Tanveer, M.; Saeed, S. Impact of fertilizer use on weed management in conservation agriculture—A Review. Pak. J. Agric. Res. 2014, 27, 161–171. [Google Scholar]
- Hillocks, R.J. The potential benefits of weeds with reference to small holder agriculture in Africa. Integr. Pest Manag. Rev. 1998, 3, 155–167. [Google Scholar] [CrossRef]
- Norris, R.; Kogan, M. Interactions between weeds, arthropod pests, and their natural enemies in managed ecosystems. Weed Sci. 2000, 48, 94–158. [Google Scholar] [CrossRef]
- Madden, M.K.; Widick, I.V.; Blubaugh, C.K. Weeds impose unique outcomes for pests, natural enemies, and yield in two vegetable crops. Environ. Entomol. 2021, 50, 330–336. [Google Scholar] [CrossRef] [PubMed]
- Jabran, K.; Mahajan, G.; Sardana, V.; Chauhan, B.S. Allelopathy for weed control in agricultural systems. Crop Prot. 2015, 72, 57–65. [Google Scholar] [CrossRef]
- Heap, I. The International Herbicide-Resistant Weed Database. Available online: www.weedscience.org (accessed on 11 January 2021).
- Barratt, B.I.P.; Moran, V.C.; Bigler, F.; van Lenteren, J.C. The status of biological control and recommendations for improving uptake for the future. BioControl 2018, 63, 155–167. [Google Scholar] [CrossRef] [Green Version]
- MacLaren, C.; Storkey, J.; Menegat, A.; Metcalfe, H.; Dehnen-Schmutz, K. An ecological future for weed science to sustain crop production and the environment. A review. Agron. Sustain. Dev. 2020, 40, 24–52. [Google Scholar] [CrossRef]
- Bhadoria, P.B.S. Allelopathy: A natural way towards weed management. Am. J. Exp. Agric. 2011, 1, 7–20. [Google Scholar] [CrossRef]
- Bertin, C.; Yang, X.H.; Weston, L.A. The role of root exudates and allelochemicals in the rhizosphere. Plant Soil 2003, 256, 67–83. [Google Scholar] [CrossRef]
- Weir, T.L.; Park, S.W.; Vivanco, J.M. Biochemical and physiological mechanisms mediated by allelochemicals. Curr. Opin. Plant Biol. 2004, 7, 472–479. [Google Scholar] [CrossRef] [PubMed]
- Belz, R.G. Allelopathy in crop/weed interactions—An update. Pest Manag. Sci. 2007, 63, 308–326. [Google Scholar] [CrossRef] [PubMed]
- Uchino, H.; Iwama, K.; Jitsuyama, Y.; Ichiyama, K.; Yudate, T.; Nakamura, S.; Gopal, J. Effect of interseeding cover crops and fertilization on weed suppression under an organic and rotational cropping system: 1. Stability of weed suppression over years and main crops of potato, maize and soybean. Field Crop. Res. 2012, 127, 9–16. [Google Scholar] [CrossRef] [Green Version]
- Mahmoodzadeh, H.; Mahmoodzadeh, M. Allelopathic effects of rhizome aqueous extract of Cynodondactylon L. on seed germination and seedling growth of legumes, Labiatae and Poaceae. Iran. J. Plant Physiol. 2014, 4, 1047–1054. [Google Scholar]
- El Zahar Haichar, F.; Santaella, C.; Heulin, T.; Achouak, W. Root exudates mediated interactions belowground. Soil Biol. Biochem. 2014, 77, 69–80. [Google Scholar] [CrossRef]
- Alcántara, C.; Pujadas, A.; Saavedra, M. Management of cruciferous cover crops by mowing for soil and water conservation in southern Spain. Agric. Water Manag. 2011, 98, 1071–1080. [Google Scholar] [CrossRef]
- Narwal, S.S. Weed management in rice: Wheat rotation by allelopathy. CRC Crit. Rev. Plant Sci. 2000, 19, 249–266. [Google Scholar] [CrossRef]
- Hatcher, P.E.; Melander, B. Combining physical, cultural and biological methods: Prospects for integrated non-chemical weed management strategies. Weed Res. 2003, 43, 302–322. [Google Scholar] [CrossRef]
- Wu, H.; Pratley, H.; Lemerle, D.; Haig, T. Crop cultivars with allelopathic capability. Weed Res. 1999, 39, 171–180. [Google Scholar] [CrossRef]
- Duke, S.O.; Scheffler, B.E.; Dayan, F.E.; Weston, L.A.; Ota, E. Strategies for using transgenes to produce allelopathic crops. Weed Technol. 2001, 15, 826–834. [Google Scholar] [CrossRef]
- Li, Z.-H.; Wang, Q.; Ruan, X.; Pan, C.-D.; Jiang, D.-A. Phenolics and Plant Allelopathy. Molecules 2010, 15, 8933–8952. [Google Scholar] [CrossRef] [Green Version]
- Singh, H.P.; Batish, D.R.; Kohli, R.K. Allelopathic interactions and allelochemicals: New possibilities for sustainable weed management. Crit. Rev. Plant Sci. 2003, 22, 239–311. [Google Scholar] [CrossRef]
- Khanh, T.D.; Elzaawely, A.A.; Chung, I.M.; Ahn, J.K.; Tawata, S.; Xuan, T.D. Role of allelochemical for weed management in rice. Allelopath. J. 2007, 19, 85–96. [Google Scholar]
- Kovacik, J.; Klejdus, B.; Backor, M.; Repcak, M. Phenylalanine ammonia-lyase activity and phenolic compounds accumulation in nitrogen-deficient Matricaria chamomilla leaf rosettes. Plant Sci. 2007, 172, 393–399. [Google Scholar] [CrossRef]
- Hussain, M.I.; Reigosa, M.J. Allelochemical stress inhibits growth, leaf water relations, PSII photochemistry, non-photochemical fluorescence quenching, and heat energy dissipation in three C3 perennial species. J. Exp. Bot. 2011, 62, 4533–4545. [Google Scholar] [CrossRef]
- Alsaadawi, I.S.; Sarbout, A.K.; Al-Shamma, L.M. Differential allelopathic potential of sunflower (Helianthus annuus L.) genotypes on weeds and wheat (Triticum aestivum L.) crop. Arch. Agron. Soil Sci. 2012, 58, 1139–1148. [Google Scholar] [CrossRef]
- Vyvyan, J.R. Allelochemicals as leads for new herbicides and agrochemicals. Tetrahedron 2002, 58, 1631–1646. [Google Scholar] [CrossRef]
- Singh, H.P.; Batish, D.R.; Pandher, J.K.; Kohli, R.K. Assessment of allelopathic properties of Parthenium hysterophorus residues. Agric. Ecosyst. Environ. 2003, 95, 537–541. [Google Scholar] [CrossRef]
- Batish, R.D.; Setia, N.; Singh, H.P.; Kohli, R.K. Phytotoxicity of lemon-scented eucalypt oil and its potential use as a bioherbicide. Crop Prot. 2004, 23, 1209–1214. [Google Scholar] [CrossRef]
- Macías, F.A.; Chinchilla, N.; Varela, R.M.; Molinillo, J.M.G. Bioactive steroids from Oryza sativa L. Steroids 2006, 71, 603–608. [Google Scholar] [CrossRef]
- Khan, M.A.; Afridi, R.A.; Hashim, S.; Khattak, A.M.; Ahmad, Z.; Wahid, F.; Chauhan, B.S. Integrated effect of allelochemicals and herbicides on weed suppression and soil microbial activity in wheat (Triticum aestivum L.). Crop Prot. 2016, 90, 34–39. [Google Scholar] [CrossRef]
- Carrubba, A.; Labruzzo, A.; Comparato, A.; Muccilli, S.; Spina, A. Use of Plant Water Extracts for Weed Control in Durum Wheat (Triticum turgidum L. subsp. durum Desf.). Agronomy 2020, 10, 364. [Google Scholar] [CrossRef] [Green Version]
- Khan, T.D.; Hong, N.H.; Xuan, T.D.; Chung, I.M. Paddy weed control by medicinal and leguminous plants from Southeast Asia. Crop Prot. 2005, 24, 421–431. [Google Scholar] [CrossRef]
- Anjum, T.; Bajwa, R. The effect of sunflower leaf extracts on Chenopodium album in wheat fields in Pakistan. Crop Prot. 2007, 26, 1390–1394. [Google Scholar] [CrossRef]
- Amini, S.; Azizi, M.; Joharchi, M.R.; Shafei, M.N.; Moradinezhad, F.; Fujii, Y. Determination of allelopathic potential in some medicinal and wild plant species of Iran by dish pack method. Theor. Exp. Plant Physiol. 2014, 26, 189–199. [Google Scholar] [CrossRef]
- Weston, L.A. Utilization of allelopathy for weed management in agroecosystems. Agron. J. 1996, 88, 860–866. [Google Scholar] [CrossRef]
- Synowiec, A.; Nowicka-Połeć, A. Effect of aqueous extracts of selected medicinal plants on germination of windgrass [Apera spica-venti (L.) P. Beauv.] and lambsquarters (Chenopodium album L.) seeds. Acta Agrobot. 2016, 69, 1668–1676. [Google Scholar] [CrossRef] [Green Version]
- Cheng, F.; Cheng, Z. Research Progress on the use of Plant Allelopathy in Agriculture and the Physiological and Ecological Mechanisms of Allelopathy. Front. Plant Sci. 2015, 6, 1020. [Google Scholar] [CrossRef]
- Jop, B.; Wawrzyńczak, K.; Polaszek, K.; Synowiec, A. Analysis of the sensitivity of spring wheat and white mustard seedlings to the essential oil of parsley seeds. Biol. Life Sci. Forum 2021, 3, 12. [Google Scholar] [CrossRef]
- Carré, P.; Pouzet, A. Rapeseed market, worldwide and in Europe. OCL 2014, 21, D102–D113. [Google Scholar] [CrossRef]
- Jankowski, K.J.; Załuski, D.; Sokólski, M. Canola-quality white mustard: Agronomic management and seed yield. Ind. Crop. Prod. 2020, 145, 112138–112146. [Google Scholar] [CrossRef]
- Woźniak, E.; Waszkowska, E.; Zimny, T.; Sowa, S.; Twardowski, T. The rapeseed potential in Poland and Germany in the context of production, legislation, and intellectual property rights. Front. Plant Sci. 2019, 10, 1423. [Google Scholar] [CrossRef] [PubMed] [Green Version]
- Anioł–Kwiatkowska, J. Plants in Human Life and Environmental Protection. [Rośliny w Życiu Człowieka i Ochronie Środowiska (In Polish)]; Wydawnictwo Uniwersytetu Wrocławskiego: Wrocław, Poland, 1995. [Google Scholar]
- Broda, B.; Mowszowicz, J. Guide to the Labeling of Medicinal, Poisonous and Utility Plants. [Przewodnik do Oznaczania Roślin Leczniczych, Trujących i Użytkowych (In Polish)]; Wydawnictwo Lekarskie PZWL: Warszawa, Poland, 1966. [Google Scholar]
- Grau, J.; Jung, R.; Muenker, B. Herbs and Forest Fruits. [Zioła i Owoce Leśne (In Polish)]; Świat Książki: Warszawa, Poland, 1996. [Google Scholar]
- Mikołajczyk, K.; Wierzbicki, A. Herbs As a Source of Health. [Zioła Źródłem Zdrowia (In Polish)]; Oficyna Wydawniczo—Poligraficzna Adam: Warszawa, Poland, 1999. [Google Scholar]
- Ody, P. Great Medical Herbarium. [Wielki Zielnik Medyczny (In Polish)]; Wydawnictwo Debit: Bielsko-Biała, Poland, 1993. [Google Scholar]
- Rumińska, A. Medicinal Plants: Basics of Biology and Agrotechnics. [Rośliny Lecznicze: Podstawy Biologii i Agrotechniki (In Polish)]; Polskie Wydawnictwo Naukowe: Warszawa, Poland, 1983. [Google Scholar]
- Macias, F.A.; Torres, A.; Molinillo, J.M.G.; Varela, R.M.; Castellano, D. Potential allelopathic sesquiterpene lactones from sunflower leaves. Phytochemistry 1996, 43, 1205–1215. [Google Scholar] [CrossRef]
- Macias, F.A.; Molinillo, J.M.G.; Torres, A.; Varela, R.M.; Castellano, D. Bioactive flavonoids from Helianthus annus cultivars. Phytochemistry 1997, 45, 683–687. [Google Scholar] [CrossRef]
- Macias, F.A.; Varela, R.M.; Torres, A.; Oliva, R.M.; Molinillo, J.M.G. Bioactive norsesquiterpenes from Helianthus annus with potential allelopathic activity. Phytochemistry 1998, 48, 631–636. [Google Scholar] [CrossRef]
- Macias, F.A.; Torres, A.; Galindo, J.L.G.; Varela, R.M.; A’lvares, J.A.; Molinillo, J.M.G. Bioactive terpenoids from sunflower leaves cv. Peredovick®. Phytochemistry 2002, 61, 687–692. [Google Scholar] [CrossRef]
- Kupidłowska, E.; Gniazdowska, A.; Stępień, J.; Corbineau, F.; Vinel, D.; Skoczowski, A.; Janeczko, A.; Bogatek, R. Impact of sunflower (Helianthus annus L.) extracts upon reserve mobilization and energy metabolism in germinating mustard (Sinapis alba L.) seeds. J. Chem. Ecol. 2006, 32, 2569–2583. [Google Scholar] [CrossRef] [PubMed]
- Skoczowski, A.; Janeczko, A.; Gullner, G.; Tobias, I.; Kornas, A.; Barna, B. Response of brassinosteroid-treated oilseed rape cotyledons to infection with the wild type and HR-mutant of Pseudomonas syringae or with P. fluorescence. J. Thermal Anal. Calorim. 2011, 104, 131–139. [Google Scholar] [CrossRef]
- Stokłosa, A.; Janeczko, A.; Skoczowski, A.; Kieć, J. Isothermal calorimetry as a tool for estimating resistance of wild oat (Avena fatua L.) to aryloxyphenoxypropionate herbicides. Thermochim. Acta 2006, 441, 203–206. [Google Scholar] [CrossRef]
- Troć, M.; Skoczowski, A.; Barańska, M. The influence of sunflower and mustard leaf extracts on the germination of mustard seeds. J. Thermal Anal. Calorim. 2009, 95, 727–730. [Google Scholar] [CrossRef]
- Dikić, M. Allelopathic effect of the extract of aromatic and medicinal plants on germination of weed seeds. In Proceedings of the 11th European Weed Research Society Symposium, Warwick: European Weed Research Society, Basel, Switzerland, 28 June—1 July 1999; p. 75. [Google Scholar]
- Jafarpoor, R.; Tajbakhsh, M.; Eivazi, A.R. The allelopathic effects of Sinapsis alba L., Achillea millefolium L., Salvia nemorosa L., Artemisia incana L. and walnut leaf on red bean (Phaselous coccineus L.). Iran. J. Field Crop. Res. 2011, 9, 39–49. [Google Scholar]
- Oracz, K.; Bailly, C.; Gniazdowska, A.; Côme, D.; Corbineau, F.; Bogatek, R. Induction of oxidative stress by sunflower phytotoxins in germinating mustard seeds. J. Chem. Ecol. 2007, 33, 251–264. [Google Scholar] [CrossRef] [PubMed] [Green Version]
- Synowiec, A.; Kalemba, D.; Drozdek, E.; Bocianowski, J. Phytotoxic potential of essential oils from temperate climate plants against the germination of selected weeds and crops. J. Pest Sci. 2017, 90, 407–419. [Google Scholar] [CrossRef]
- Duke, S.O. Proving allelopathy in crop–weed interactions. Weed Sci. 2015, 63, 121–132. [Google Scholar] [CrossRef] [Green Version]
- Inderjit; Nilsen, E.T. Bioassays and field studies for allelopathy in terrestrial plants: Progress and problems. Crit. Rev. Plant Sci. 2003, 22, 221–238. [Google Scholar] [CrossRef]
- Janeczko, A.; Tóbias, I.; Skoczowski, A.; Dubert, F.; Gullner, G.; Barna, B. Bacterial infection and pretreatment with 24-epibrassinolide markedly affect the heat emission and membrane permeability of rape cotyledons. Thermoch. Acta 2007, 458, 89–91. [Google Scholar] [CrossRef]
- Janeczko, A.; Gullner, G.; Skoczowski, A.; Dubert, F.; Barna, B. Effects of brassinosteroid infiltration prior to cold treatment on ion leakage and pigment contents in rape leaves. Biol. Plant. 2007, 51, 355–358. [Google Scholar] [CrossRef]
- Eremina, M.; Unterholzner, S.J.; Rathnayake, A.I.; Castellanos, M.; Khan, M.; Kugler, K.G.; May, S.T.; Mayer, K.F.X.; Rozhon, W.; Poppenberger, B. Brassinosteroids participate in the control of basal and acquired freezing tolerance of plants. Proc. Nat. Acad. Sci. USA 2016, 113, 5982–5991. [Google Scholar] [CrossRef] [Green Version]
- Creencia, R.P.; Bramlage, W.J. Reversibility of chilling injury to corn seedlings. Plant Physiol. 1971, 47, 389–392. [Google Scholar] [CrossRef] [PubMed] [Green Version]
- Einhellig, F.A. Allelopathy: Current status and future goals. In Allelopathy: Organisms, Processes and Applications.; Inderjit, Dakshini, K.M.M., Einhellig, F.A., Eds.; ACS Symposium Series 582; American Chemical Society: Washington, DC, USA, 1995; pp. 1–24. [Google Scholar]
- Scandalios, J.G. Oxygen stress and superoxide dismutase. Plant Physiol. 1993, 101, 7–12. [Google Scholar] [CrossRef] [Green Version]
- Foyer, C.H.; Descourvieres, P.; Kunert, K.J. Protection against oxygen radicals: An importantdefence mechanism studied in transgenic plants. Plant Cell Environ. 1994, 17, 507–523. [Google Scholar] [CrossRef]
- Skoczowski, A.; Troć, M. Isothermal calorimetry and Raman spectroscopy to study response of plants to abiotic and biotic stress. In Molecular Stress Physiology of Plants; Rout, G.R., Das, A.B., Eds.; Springer: New Delhi, India, 2013; pp. 263–288. [Google Scholar]
- Schabes, F.I.; Sigstad, E.E. Optimizing conditions to study seed germination by calorimetry using soybean (Glycine max [L.] Merr.) seeds. Thermochim. Acta 2006, 450, 96–101. [Google Scholar] [CrossRef]
- Saja, D.; Rys, M.; Stokłosa, A.; Skoczowski, A. Physiological tests for early detection of rigid ryegrass (Lolium rigidum goud.) resistance to fenoxaprop-p. Acta Physiol. Plant. 2014, 36, 485–491. [Google Scholar] [CrossRef] [Green Version]
- Schabes, F.I.; Sigstad, E.E. A calorimetric study of the allelopathic effect of cnicin isolated from Centaurea diffusa Lam. on the germination of soybean (Glicine max) and radish (Raphanus sativus). Thermochim. Acta 2007, 458, 84–87. [Google Scholar] [CrossRef]
- Skoczowski, A.; Troć, M.; Baran, A.; Baranska, M. Impact of sunflower and mustard leave extracts on the growth and dark respiration of mustard seedlings. J. Thermal Anal. Calorim. 2011, 104, 187–192. [Google Scholar] [CrossRef]
- Troć, M.; Saja, D.; Kornas, A.; Żuraw, A.; Skoczowski, A. Strong endothermic effects caused by allelopathic interactions during growth of mustard, rape, wheat and clover seedlings. J. Thermal Anal. Calorim. 2011, 104, 141–148. [Google Scholar] [CrossRef]
- Synowiec, A.; Możdżeń, K.; Skoczowski, A. Early physiological response of broccoli leaf to foliar application of clove oil and its main constituents. Ind. Crop. Prod. 2015, 74, 523–529. [Google Scholar] [CrossRef]
- Abrahim, D.; Braguini, W.L.; Kelmer-Bracht, A.M.; Ishii-Iwamoto, E.L. Effects of four monoterpenes on germination, primary root growth and mitochondrial respiration of maize. J. Chem. Ecol. 2000, 26, 611–624. [Google Scholar] [CrossRef]
- Edelstein, M.; Bradford, K.J.; Burger, D.W. Metabolic heat and CO2 production rates during germination of melon (Cucumis melo L.) seeds measured by microcalorimetry. Seed Sci. Res. 2001, 11, 265–272. [Google Scholar]
- Sigstad, E.E.; Prado, F.E. A microcalorimetric study of Chenopodium quinoa Willd. seeds germination. Thermochim. Acta 1999, 326, 159–164. [Google Scholar] [CrossRef]
- Sadeghi-Jorabchi, H.; Hendra, P.J.; Wilson, R.H.; Belton, P.S. Determination of the total unsaturation in oils and margarines by Fourier transform Raman spectroscopy. J. Am. Oil Chem. Soc. 1990, 67, 483–486. [Google Scholar] [CrossRef]
- Sadeghi-Jorabchi, H.; Wilson, R.H.; Belton, P.S.; Edward-Webb, J.D.; Coxon, D.T. Quantitative analysis of oils and fats by Fourier-transform Raman spectroscopy. Spectrochim. Acta A 1991, 47, 1449–1458. [Google Scholar] [CrossRef]
- Dibofori, A.N.; Okoh, A.N.; Onigbinde, A.O. Effect of germination on the cyanide and oligosaccharide content of Lima beans (Phaseolus lanatus L.). Food Chem. 1994, 51, 133–136. [Google Scholar] [CrossRef]
- Offem, J.O.; Egbe, E.O.; Onen, A.I. Changes in lipid content and composition during germination of groundnuts. J. Sci. Food Agric. 1993, 62, 147–155. [Google Scholar] [CrossRef]
- Yaniv, Z.; Shabelsky, E.; Schafferman, D.; Granot, I.; Kipnis, T. Oil and fatty acid changes in Sinapis and Crambe seeds during germination and early development. Ind. Crop. Prod. 1998, 9, 1–8. [Google Scholar] [CrossRef]
- Pietta, P.-G. Flavonoids as antioxidants. J. Nat. Prod. 2000, 63, 1035–1042. [Google Scholar] [CrossRef] [PubMed]

Publisher’s Note: MDPI stays neutral with regard to jurisdictional claims in published maps and institutional affiliations. |
© 2022 by the authors. Licensee MDPI, Basel, Switzerland. This article is an open access article distributed under the terms and conditions of the Creative Commons Attribution (CC BY) license (https://creativecommons.org/licenses/by/4.0/).
Share and Cite
Rys, M.; Saja-Garbarz, D.; Skoczowski, A. Phytotoxic Effects of Selected Herbal Extracts on the Germination, Growth and Metabolism of Mustard and Oilseed Rape. Agronomy 2022, 12, 110. https://doi.org/10.3390/agronomy12010110
Rys M, Saja-Garbarz D, Skoczowski A. Phytotoxic Effects of Selected Herbal Extracts on the Germination, Growth and Metabolism of Mustard and Oilseed Rape. Agronomy. 2022; 12(1):110. https://doi.org/10.3390/agronomy12010110
Chicago/Turabian StyleRys, Magdalena, Diana Saja-Garbarz, and Andrzej Skoczowski. 2022. "Phytotoxic Effects of Selected Herbal Extracts on the Germination, Growth and Metabolism of Mustard and Oilseed Rape" Agronomy 12, no. 1: 110. https://doi.org/10.3390/agronomy12010110
APA StyleRys, M., Saja-Garbarz, D., & Skoczowski, A. (2022). Phytotoxic Effects of Selected Herbal Extracts on the Germination, Growth and Metabolism of Mustard and Oilseed Rape. Agronomy, 12(1), 110. https://doi.org/10.3390/agronomy12010110

